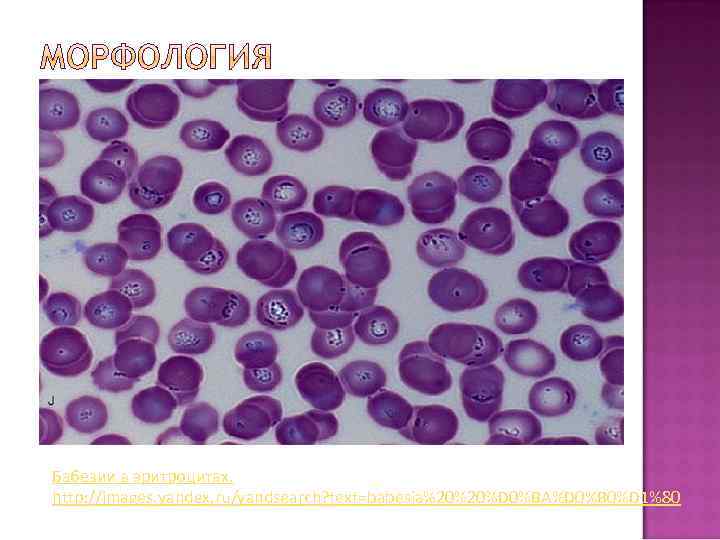
Бабезии в эритроцитах. http: //images. yandex. ru/yandsearch? text=babesia%20%20%D 0%BA%D 0%B 0%D 1%80

Выполнила: Адищева В. БМ 501 (2)

Тип Простейшие Класс Споровики Отряд Piroplasmida Семейство Babesiidae Род Babesia Вид Babesia caucasica Вид Babesia divergens Вид Babesia microti Вид Babesia bovis
Бабезии в эритроцитах. http: //images. yandex. ru/yandsearch? text=babesia%20%20%D 0%BA%D 0%B 0%D 1%80

На территории бывшего СССР наиболее частыми районами распространения бабезиоза являются сельские районы Крыма, стран СНГ, Северного Кавказа и Средней Азии, а также юг Украины.

• • Естественным резервуаром возбудителей в природе служат больные бабезиозом животные. Механизм передачи: трансмиссивный, гемотрансфузионный Переносчики: клещи семейства Ixodidae, клещи родов Dermacentor, Rhipicephalus, Hyalomma. Восприимчивый коллектив: люди, контактирующие с клещами (сельскохозяйственные рабочие, туристы, пастухи и др. ).

Бабезии проникают в капиляры в месте укуса Размножение в крови бинарным делением Разрушение эритроцитов Возникновение анемии, гипоксии тканей Тяжелые нарушения выделительной, сердечно-сосудистой системы, центральной нервной системы.

Инкубационный период 2 -4 недели. Основные симптомы: Лихорадка с ознобом Слабость Желтушность склер и кожи Гемоглобинурия Почечная недостаточность

1. 2. 3. 4. Микроскопия ПЦР Непрямая иммунофлюоресценция Биологический метод

Рекомендуются комбинации клиндамицина и хинина или азитромицина и атоваквона. В более серьезных случаях эффективным средством для спасения жизни больного является переливание крови. http: //images. yandex. ru/yandsearch? textnor eask=1&img_url=www. soundbook. ru%2 Fblo g%2 Fwpcontent%2 Fuploads%2 Fd 59 d%2 Fi mg

Вакцины не разработаны. Применении антипротозойных препаратов: азидин, беренил, верибен. применение инсектоакарицидных препаратов http: //images. yandex. ru/yandsearch? text=%_url=www. vettorg. n et%2 Fimg%2 Fnews%2 Fpict_0071. jpg&pos=6&rpt=simage

Применение противопаразитарных ошейников, аэрозолей и прочих способов борьбы с клещамипереносчиками возбудителей данного заболевания http: //images. yandex. ru/yandsearch? text=%p 1 ai%2 Fimages%2 Fbiof 150. gif&pos=28&rpt=simage

Спасибо за внимание!